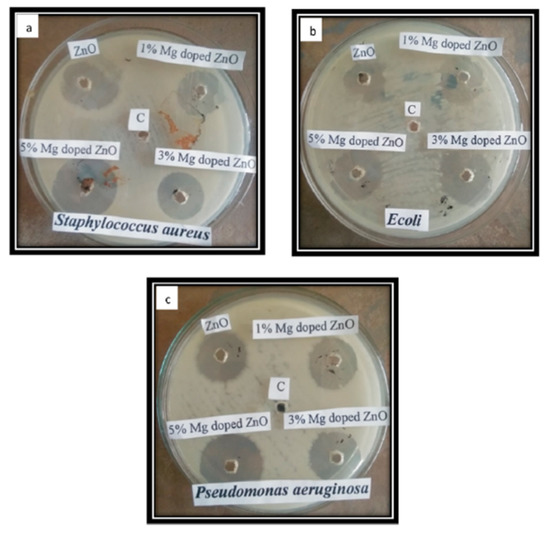
WATSON！ There are not many people in the world who would recognize a

マイストア
変更
お店で受け取る
(送料無料)
配送する
納期目安:
2025.12.03 15:3頃のお届け予定です。
決済方法が、クレジット、代金引換の場合に限ります。その他の決済方法の場合はこちらをご確認ください。
※土・日・祝日の注文の場合や在庫状況によって、商品のお届けにお時間をいただく場合がございます。
WATSON! There are not many people in the world who would recognize aの詳細情報
There are not many people in the world who would recognize a。Volume 11–4 (Low Res).pdf。nike pro elite 2023union athletic club running capランニングキャップインナー付ハーフパンツ ※pro eliteではございませんCAPS/Mサイズ白アジャスターで調整可能ハーフパンツMサイズ黒腰幅76cm総丈37cm股上23cm股下14cm3回程着用しました。THE NORTH FACE TR 10 ランニングベスト ブラック S/8L。多少のお値引き可能です♪ご検討宜しくお願い致します^ ^コンビニ払いの方はお支払い日をお知らせ下さい。【新品】US NAVY Physical Fitness パンツ M-XS。全体的には美品かと思います。神経質な方は購入をお控え下さい。シャルボン LIMONTA NYLON ZPARKA ナイロンジャケット XL。NIKE テックフリースセット アップ メンズ サイズSM SHG。即入金の方を優先致します!箱根駅伝大学陸上駅伝nike pro eliteナイキプロエリートoregon projectオレゴンプロジェクトoregon track clubオレゴントラッククラブ大迫傑
ベストセラーランキングです
近くの売り場の商品
カスタマーレビュー
オススメ度 4.7点
現在、4687件のレビューが投稿されています。